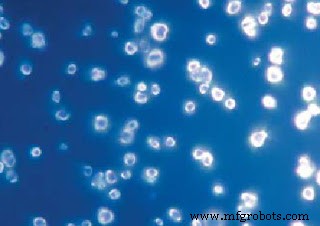
Nanodiamonds: Ultra‑Precise Magnetic Sensors for Biomedical and Quantum Applications

Nanodiamonds: Ultra‑Precise Magnetic Sensors for Biomedical and Quantum Applications
Nanodiamonds
Nanodiamonds
Nanodiamonds are diamond‑structured particles smaller than 10 nm, formed as a residue when TNT or Hexogen detonates in a confined environment. Their exceptional mechanical strength, optical clarity, high surface area, and tunable surface chemistry make them ideal for a broad spectrum of applications, from tribology and drug delivery to bio‑imaging and tissue engineering. Because they are non‑toxic and can mimic proteins, nanodiamonds are also used as fillers in nanocomposites and in various high‑performance industries such as aerospace, precision machining, optics, automotive manufacturing, and advanced lubricants.
Measuring Magnetic Fields
Researchers at the University of California, Santa Barbara have pioneered an electron‑spin resonance (ESR) approach that couples nanodiamonds with lasers to quantify local magnetic fields in liquid media.
Technique
The method exploits the nitrogen‑vacancy (NV) centers in nanodiamonds. A tightly focused laser beam forms an optical tweezer that attracts the dielectric particles to its focal point, levitating and trapping them without physical contact. By translating the laser focus through the fluid, the particles can be positioned with nanometer precision. ESR measurements then probe the energy‑level structure of the NV centers via the Zeeman effect, revealing the surrounding magnetic field with high sensitivity.
Uses
This all‑optical, wire‑free sensor platform can monitor diverse phenomena, including intracellular processes, electrochemical cells, surface catalysis, and lipid membranes. It also offers the possibility of visualizing electromagnetic fields around neurons and other biological structures that are challenging to probe with conventional techniques. Thanks to their long spin‑coherence times even at room temperature, NV centers serve as reliable quantum probes, enabling repeated read‑out and re‑initialization. The nanodiamonds can be positioned anywhere within a sample, tracked, and tagged, opening new avenues in sub‑micron biophysical research.
Nanomaterials
- Detecting AC Magnetic Fields with a Coil and Audio Detector
- Understanding Magnetic Fields and Inductance: Principles, Applications, and Design
- Digital Magnetic Hall Sensors: Fundamentals, Design, and Automotive Applications
- MEMS Sensors: Powering the Invisible IoT
- Gold Nanoparticles as Advanced Chemosensors: Enhancing Electrochemical Detection
- Revolutionizing Self-Powered Wearables: Electrospun PTFE Nanofiber Membranes Deliver Unmatched Sensor Performance
- Magnetic Graphene Field‑Effect Transistor Biosensor for Ultra‑Sensitive Single‑Strand DNA Detection
- Robust Sensors for Smart Production Line Optimization
- High-Precision Eddy Current Displacement Sensors for Industrial Applications
- Advanced Magnetic Field Detection with NASA’s Fiber Bragg Grating Technology



